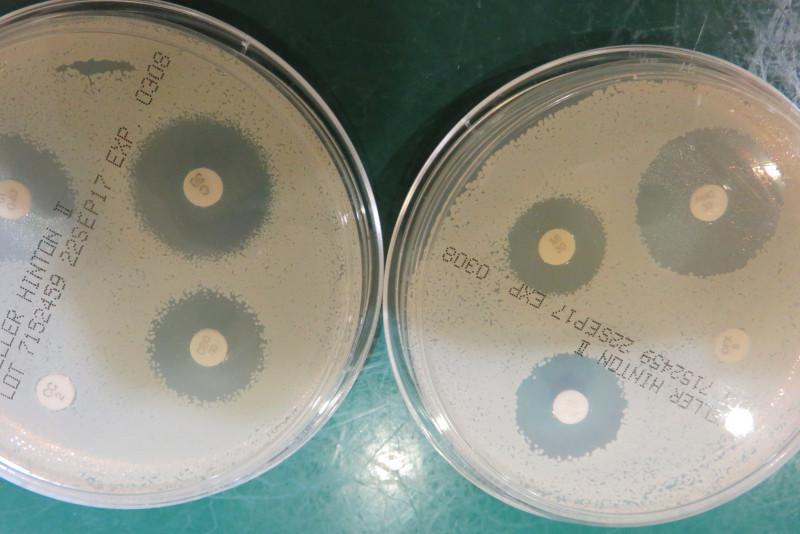
f:id:masami_takasu:20180327230702j:plain

ここは『ハナちゃんの動物病院』(猫版)です。
今日はひどい膀胱炎で来院した、猫ちゃんのお話です。
実はこの猫ちゃん、去年も同じ病気で来院して治療をしました。
なぜまた同じ病気に? それもひどい状態で?
(注:手術の写真が含まれます)

昨年の春、膀胱炎を発症し尿閉になった猫。
入院治療をしたけど、ちょっと怖がりさんで病院での治療がうまくできなかった。
尿石症なので処方食もたべなくちゃいけないし、薬も内服して欲しい。
結局、早めの退院の後、なんとなく治療が途切れてしまいどうなっていたのか分からなった。
その猫ちゃんですが――
1年ぶりにまたオシッコがでないと来院。
●
今回はかなりの重症。
尿毒症も起こしている。
尿道が詰まっていて尿道カテーテルも上手く入らない。
食べない・吐いている・オシッコでない・脱水してる。
わ~~最悪
お盆でもう休みになっちゃうし。
●
いろいろ症状が重なっているし、助けるためには手術しかないと納得してもらい、時間外の緊急手術となりました。
※以下、手術の写真が載っています。苦手な方は、閲覧にご注意を。
そして開腹。これが膀胱の外見

粘膜がガチガチに肥厚硬くなって炎症で真っ赤
●
ちなみにこれが正常な猫の膀胱の外見

正常は、うすい膜で柔軟で良く伸びることができる
●
膀胱を切開して内部を確認すると、膿まじりの粘液が充満し、かなりひどい細菌感染がある。
重度の慢性の細菌性膀胱炎になってしまっている。
尿の細菌培養と感受性試験も必須。
●
膀胱内部を生理食塩水で洗い、消炎剤を注入。
なかなか尿道確保ができず、命を救うために膀胱を腹壁に縫い付け人工の尿の出口を形成。
最終的に、尿道確保ができて会陰部尿道瘻設置術(男の子の尿の出口を女の子の出口のように広げる手術)を行うことができました。
●
これで生命の危機は避けられたけれど、慢性の膀胱炎の治療がこれからも続くわけです。
怖がりで我々スタッフをみると、ハーっと威嚇しています。
怒る元気がでてきたみたい。
●
点滴に薬を入れ、経鼻カテーテルから流動食を注入し、尿道・膀胱洗浄もやって頑張っています。

今日で手術から5日
まだまだ完治にはほど遠いし、自宅に帰ったらどうなるかが心配です。
病気によっては予防がずっと必要なものもあるし
良いようにみえても、突然悪化することもあります。
大変なのは分かるけれど、重症化してしまったら、もっともっと大変です。
病気の説明をしっかり受けて、納得して治療を受けて欲しい。
大事な家族を守るのは飼い主さんだけだからね。
膀胱炎の診察記はこちらにもあります。
● ● ●
夏野菜をいただきました
ちょっと目を離した隙にハナが・・・


ハナはダメ!!
トウモロコシアレルギーだから、
●
ハナちゃんママからアドバイス
この猫ちゃんは、会陰尿道廔の手術をして、オシッコが詰まりにくい状態にしました。それでも安心せずに、膀胱炎になりにくいよう、処方食を続けて欲しいです。
●
【Withcatより】ここでご紹介したものは、病気を疑ってみる初歩的な知識です。もしもご家庭のワンちゃん、ネコちゃんに該当する症状があったら、すぐに動物病院を受診なさってください。
▶ハナちゃんママ:犬 の診察記のご紹介
▶ハナちゃんママ:猫 の診察記のご紹介
●
――次話です――
――前話です――
●
この記事は、まとめ読みでも読むことが出来ます。
この記事は、下記の週刊Withdog&Withcatに掲載されています。
●
――ハナちゃんの動物病院(猫)・初回の記事です――
――関連記事です――
――おすすめの記事です――
――出典――
※本記事は著作者の許可を得て、下記のブログを元に再構成されたものです。

